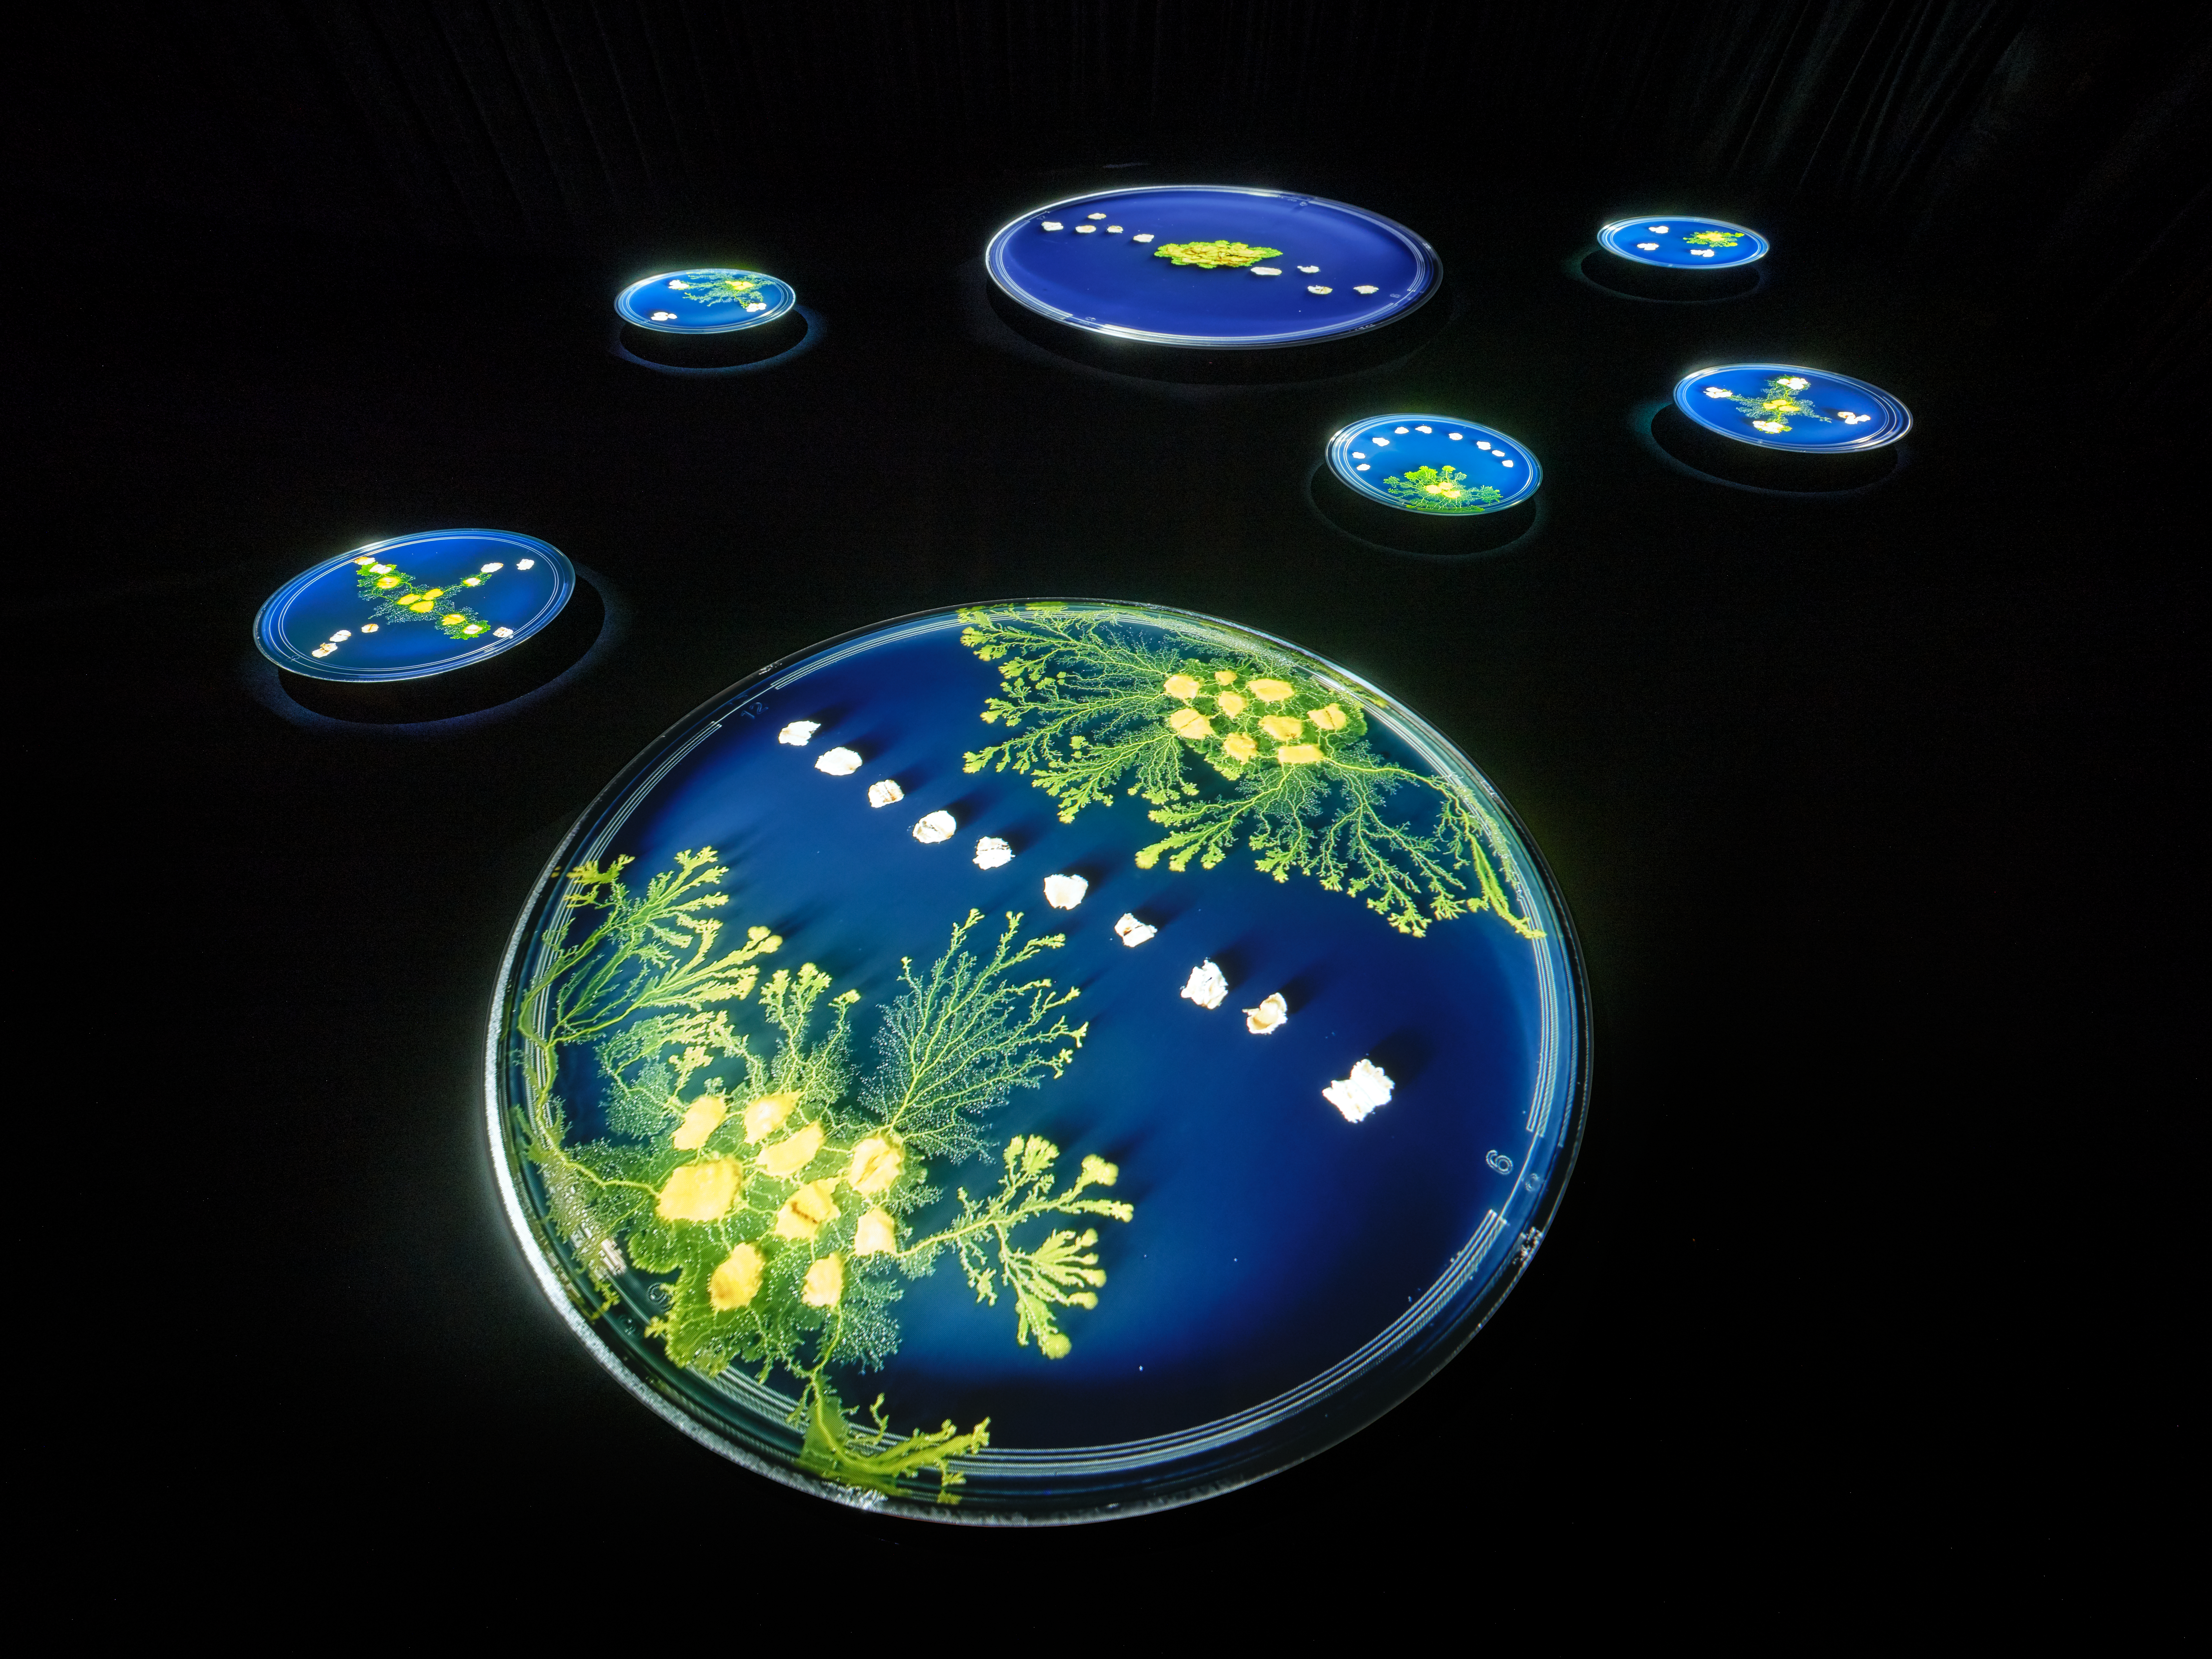
Slime Mold Traversed the Flesh

Works

2026 Parallel Forests

2026 Botanical Intelligence

2026 ENCOUNTERS

2026 xoxo-skeleton
2026 Slime Mold Traversed the Flesh

2025 ART TAIPEI 2025

2025 Oracle Womb

2025 やわらかな未来の考古学

2024 アート大阪2024

2024 DXP/DXP2

2024 獸(第2章 / BEAUTIFUL DAYDREAM)

2024 Kiaf SEOUL 2024

2024 Poltergeist

2023 CAF Award Exhibition 2023

2023 The Frankenstein Papers

2022 Art Fair Tokyo 2022

2022 ATAMI ART GRANT 2022

2022 Made in Japan 3.0: Defining a New Phy-gital Reality

2022 MaryGPT

2022 Moon?

2022 台北當代 2022

2022 UNKNOWN VISITORS

2021 Imaginary Bones

2021 絵画の見かた reprise

2021 紀南アートウィーク2021

2021 Moving Images

2020 荒れ地のアレロパシー

2020 Neighbors’ Room

2019 富士山展3.0 -冨嶽二〇二〇景-
2025 End of Chair Sculpture Styrofoam, epoxy resin, acrylic paint 2025 Oracle Womb Painting Oil paint, oil medium, acrylic medium, AI-generated image, UV print, canvas, wooden frame 2025 Orb Installation LED Matrix Panel, Microcomputer, Power Cable, Real-time Generated Image, Switching Power Supply 2025 Organs Sculpture Epoxy Resin, Fog, Paper Screen, Plaster, Real-time Generated Myth, Real-time Generated Video 2025 Untitled (Portrait With Oracle Bones) Sculpture Plaster, paper clay, AI-generated data, epoxy resin 2024 LOTUS ROOM (w/ HATRA) Installation Mixed Media 2024 Untitled (for an angel on rooftop) Installation 2024 告白のハルシネーション Painting MaryGPT, Pencile, Suggestion Box 2023 Da Vinci Phenomena Sculpture Aluminium Panel, Aluminum Honeycomb, Epoxy Resin, Galvanized Steel M6 Bolts, PVC, Thermal Print 2023 The Incomplete Author Sculpture Aluminium Panel, Aluminum Honeycomb, Epoxy Resin, Galvanized Steel M6 Bolts, PVC, Thermal Print 2023 The Lost Language of Mimir Video Triple Channels Audio, Triple Channels Video 2023 The Meal on the Last Day of Mankind Sculpture Aluminium Panel, Aluminum Honeycomb, Epoxy Resin, Galvanized Steel M6 Bolts, PVC, Thermal Print 2023 The Riddle of the Sphinx, Unriddling the Puzzles Print Colton Film, Lambda Print 2022 Parallel Portraits Sculpture Aluminum Honeycomb, Epoxy Resin, Rain, Thermal Print 2022 Pool Lily Sculpture Aluminium, Epoxy Resin, PVC, UV-curable Resin, Water 2022 Possible Roots Sculpture Epoxy Resin 2022 Tide / Time Sculpture Epoxy Resin, Salt, Sand 2022 黄昏は黄昏に似ている Painting Acrylic Photo Panel, Lambda Print 2021 big chair Sculpture Epoxy Resin, Styrofoam 2021 bones Sculpture Epoxy Resin, Styrofoam 2021 chair Sculpture Epoxy Resin, Styrofoam 2021 cinema Video Fringe Screen, Two Sofas, Video 2021 job Painting Enamel and oil paint on thermal printed aluminum plate, Epoxy Resin / Enamel and oil paint on thermal printed aluminum plate, Epoxy Resin, Wooden Frame 2021 protrusion Sculpture Epoxy Resin, Styrofoam 2021 table Sculpture Epoxy Resin, Styrofoam 2021 Utopia Video Video 2020 meta-snap Video Video 2020 Nude Hollowing A Staircase Video Video 2020 Seeds Video Video 2020 Studies on Collage of Paintings for Humanity (Bacchus and Ariadne) Digital Digital data 2020 Studies on Collage of Paintings for Humanity (Cenci) Digital Digital data 2020 Studies on Collage of Paintings for Humanity (Christ) Digital Digital data 2020 Studies on Collage of Paintings for Humanity (Ecce Homo) Digital Digital data 2020 Studies on Collage of Paintings for Humanity (Mary) Digital Digital data 2020 Studies on Collage of Paintings for Humanity (Salome) Digital Digital data 2020 The Brides (divided and rebuilt) Video Two Video, Video 2020 Three Studies Of Their Shadow Print UV print on a framed glass plate 2019 The Brides Clothed Up By You, Even Video Mixed Media, Video
2020–2025 Teebs Teebs
2024–2025 Keiichiro Shibuya 渋谷慶一郎
2025 distance.media (NTT Publishing) distance.media(NTT出版)
2023–2025 Hitsujibungaku 羊文学
2024–2025 NOTHING NEW NOTHING NEW
2025 MASU MASU
2024–2025 Daichi Miura 三浦大知
2024 LAFORET LAFORET
2020–2024 HATRA HATRA
2020–2024 Tempalay Tempalay
2023 DIESEL DIESEL
2023 CINRA CINRA
2023 King Gnu King Gnu
2022 Hatis Noit Hatis Noit
2022 KGDR KGDR
2021 KORI-SHOW PROJECT KORI-SHOW PROJECT
2021 A_o A_o
2021 RADWIMPS RADWIMPS
2020–2021 SAORI HALA SAORI HALA
2020 DAOKO DAOKO
2020 NIKE x UNDERCOVER NIKE x UNDERCOVER
2020 dosmonos dosmonos
2020 NOTEN NOTEN
2020 Memory Palace 記憶の宮殿
2020 VOGUE Italia VOGUE Italia
Publications / Contributions 著書・寄稿
2025 Eureka Jan 2026 Issue: Ari Aster — essay: 'Children of the Twilight' (Seidosha) ユリイカ2026年1月号 特集=アリ・アスター 寄稿「夕闇の子どもたち」(青土社) 2025 Eureka Special Issue: Kenjiro Okazaki — essay: 'The Twin-Companion Transformer' (Seidosha) ユリイカ臨時増刊号『総特集=岡﨑乾二郎』寄稿「比翼連理のTransformer」(青土社) 2025 Michi tono Sōzō (Creativity with the Unknown: Humanity's Alien Encounter with AI, Seibundo Shinkosha) 『未知との創造:人類とAIのエイリアン的出会いについて』(誠文堂新光社)
Lectures / Talks (Selected) 登壇・講演(抜粋)
2026 CCBT 2025 Artist Fellows Final Activity Report 'Responses to the Future Commons' (CCBT B1 Studio, Tokyo) CCBT 2025年度アーティスト・フェロー活動報告会『「これからのコモンズ」への応答』(CCBT B1スタジオ) 2026 CCBT Symposium 'Botanical/Artificial Intelligence — On Forms of Intelligence Through Plants and AI' w/ Yuko Hasegawa, Naoto Tokui, Masashi Toyoda (LIFORK HARAJUKU, Tokyo) CCBTシンポジウム『Botanical/Artificial Intelligence 植物とAIから考える知性のかたち』長谷川祐子・徳井直生・豊田正嗣と共に(LIFORK HARAJUKU) 2025 CCBT 'TALK: Cities Demand Imagination' (Tokyo, JP) CCBT『TALK:都市は、想像力を要求する。』 2025 International House of Japan, 'Interspecies Crosstalk #10: AI and Buddhism' (Tokyo, JP) 国際文化会館『異種間クロストーク #10「AIと仏教」』(六本木) 2025 CCBT Future Ideations Camp Vol.7 (Tokyo, JP) CCBT Future Ideations Camp Vol.7 2025 WIRED Futures Conference 2025: 'Future of Alien Intelligence' (Tokyo, JP) WIRED Futures Conference 2025『Future of Alien Intelligence』 2025 Japan Neuroscience Society 50th Anniversary 'NeuroArt 50' (Tokyo, JP) 日本神経科学学会50周年記念 一般公開シンポジウム「NeuroArt 50」(日本科学未来館) 2025 DOMMUNE: Kenjiro Okazaki Exhibition Special Program (Online) DOMMUNE『岡﨑乾二郎展 記念番組』出演 2025 J-WAVE 'CREATOR'S NOTE' (Radio) J-WAVE『CREATOR'S NOTE』出演 2025 Symposium 'AI and Organs' at Tokyo University of the Arts シンポジウム『AIと臓器——芸術と人間性をめぐる問い』東京藝術大学 2025 Talk events for 'Michi tono Sōzō' at √K Contemporary (w/ K. Mizuno, G. Murayama; w/ Y. Hasegawa), Junkudo Ikebukuro (w/ K. Mizuno) 『未知との創造』トークイベント:√K Contemporary(水野幸司・村山悟郎、長谷川祐子)、ジュンク堂書店池袋本店(水野幸司)
Teaching 教育
2025– Visiting Professor, Osaka University of Arts — 'AI Programming and Creation' 大阪芸術大学 客員教授(通年講義『AIプログラミングと創作』担当)
Cover Art / Media カバーアート・メディア
Selected Press / Media メディア掲載(抜粋)
2026 Media Arts Creator Support #3 (Agency for Cultural Affairs, Japan)文化庁メディア芸術クリエイター育成支援 #3 2025 Media Arts Creator Support #2 (Agency for Cultural Affairs, Japan)文化庁メディア芸術クリエイター育成支援 #2 2025 Media Arts Creator Support #1 (Agency for Cultural Affairs, Japan)文化庁メディア芸術クリエイター育成支援 #1 2025 IT HihyouIT批評 2025 ART iT 2025 Contemporary Art Foundation現代芸術振興財団 2025 Bijutsutecho #1美術手帖 #1 2025 Bijutsutecho #2美術手帖 #2 2025 WIRED.jp 2025 Ocula 2025 ARTnews JAPAN 2024 ARTnews JAPAN #1 2024 ARTnews JAPAN #2 2024 WWD JAPAN 2024 FASHIONSNAP 2024 CINRA 2023 BRUTUS 2023 Tokyo Art Beat #1 2023 Tokyo Art Beat #2 2023 TOKION 2023 artovilla #1 2023 artovilla #2 2023 Real Sound 2023 FLAB 2022 CDJournal 2022 Art PlazaArt Plaza 2021 TOKION